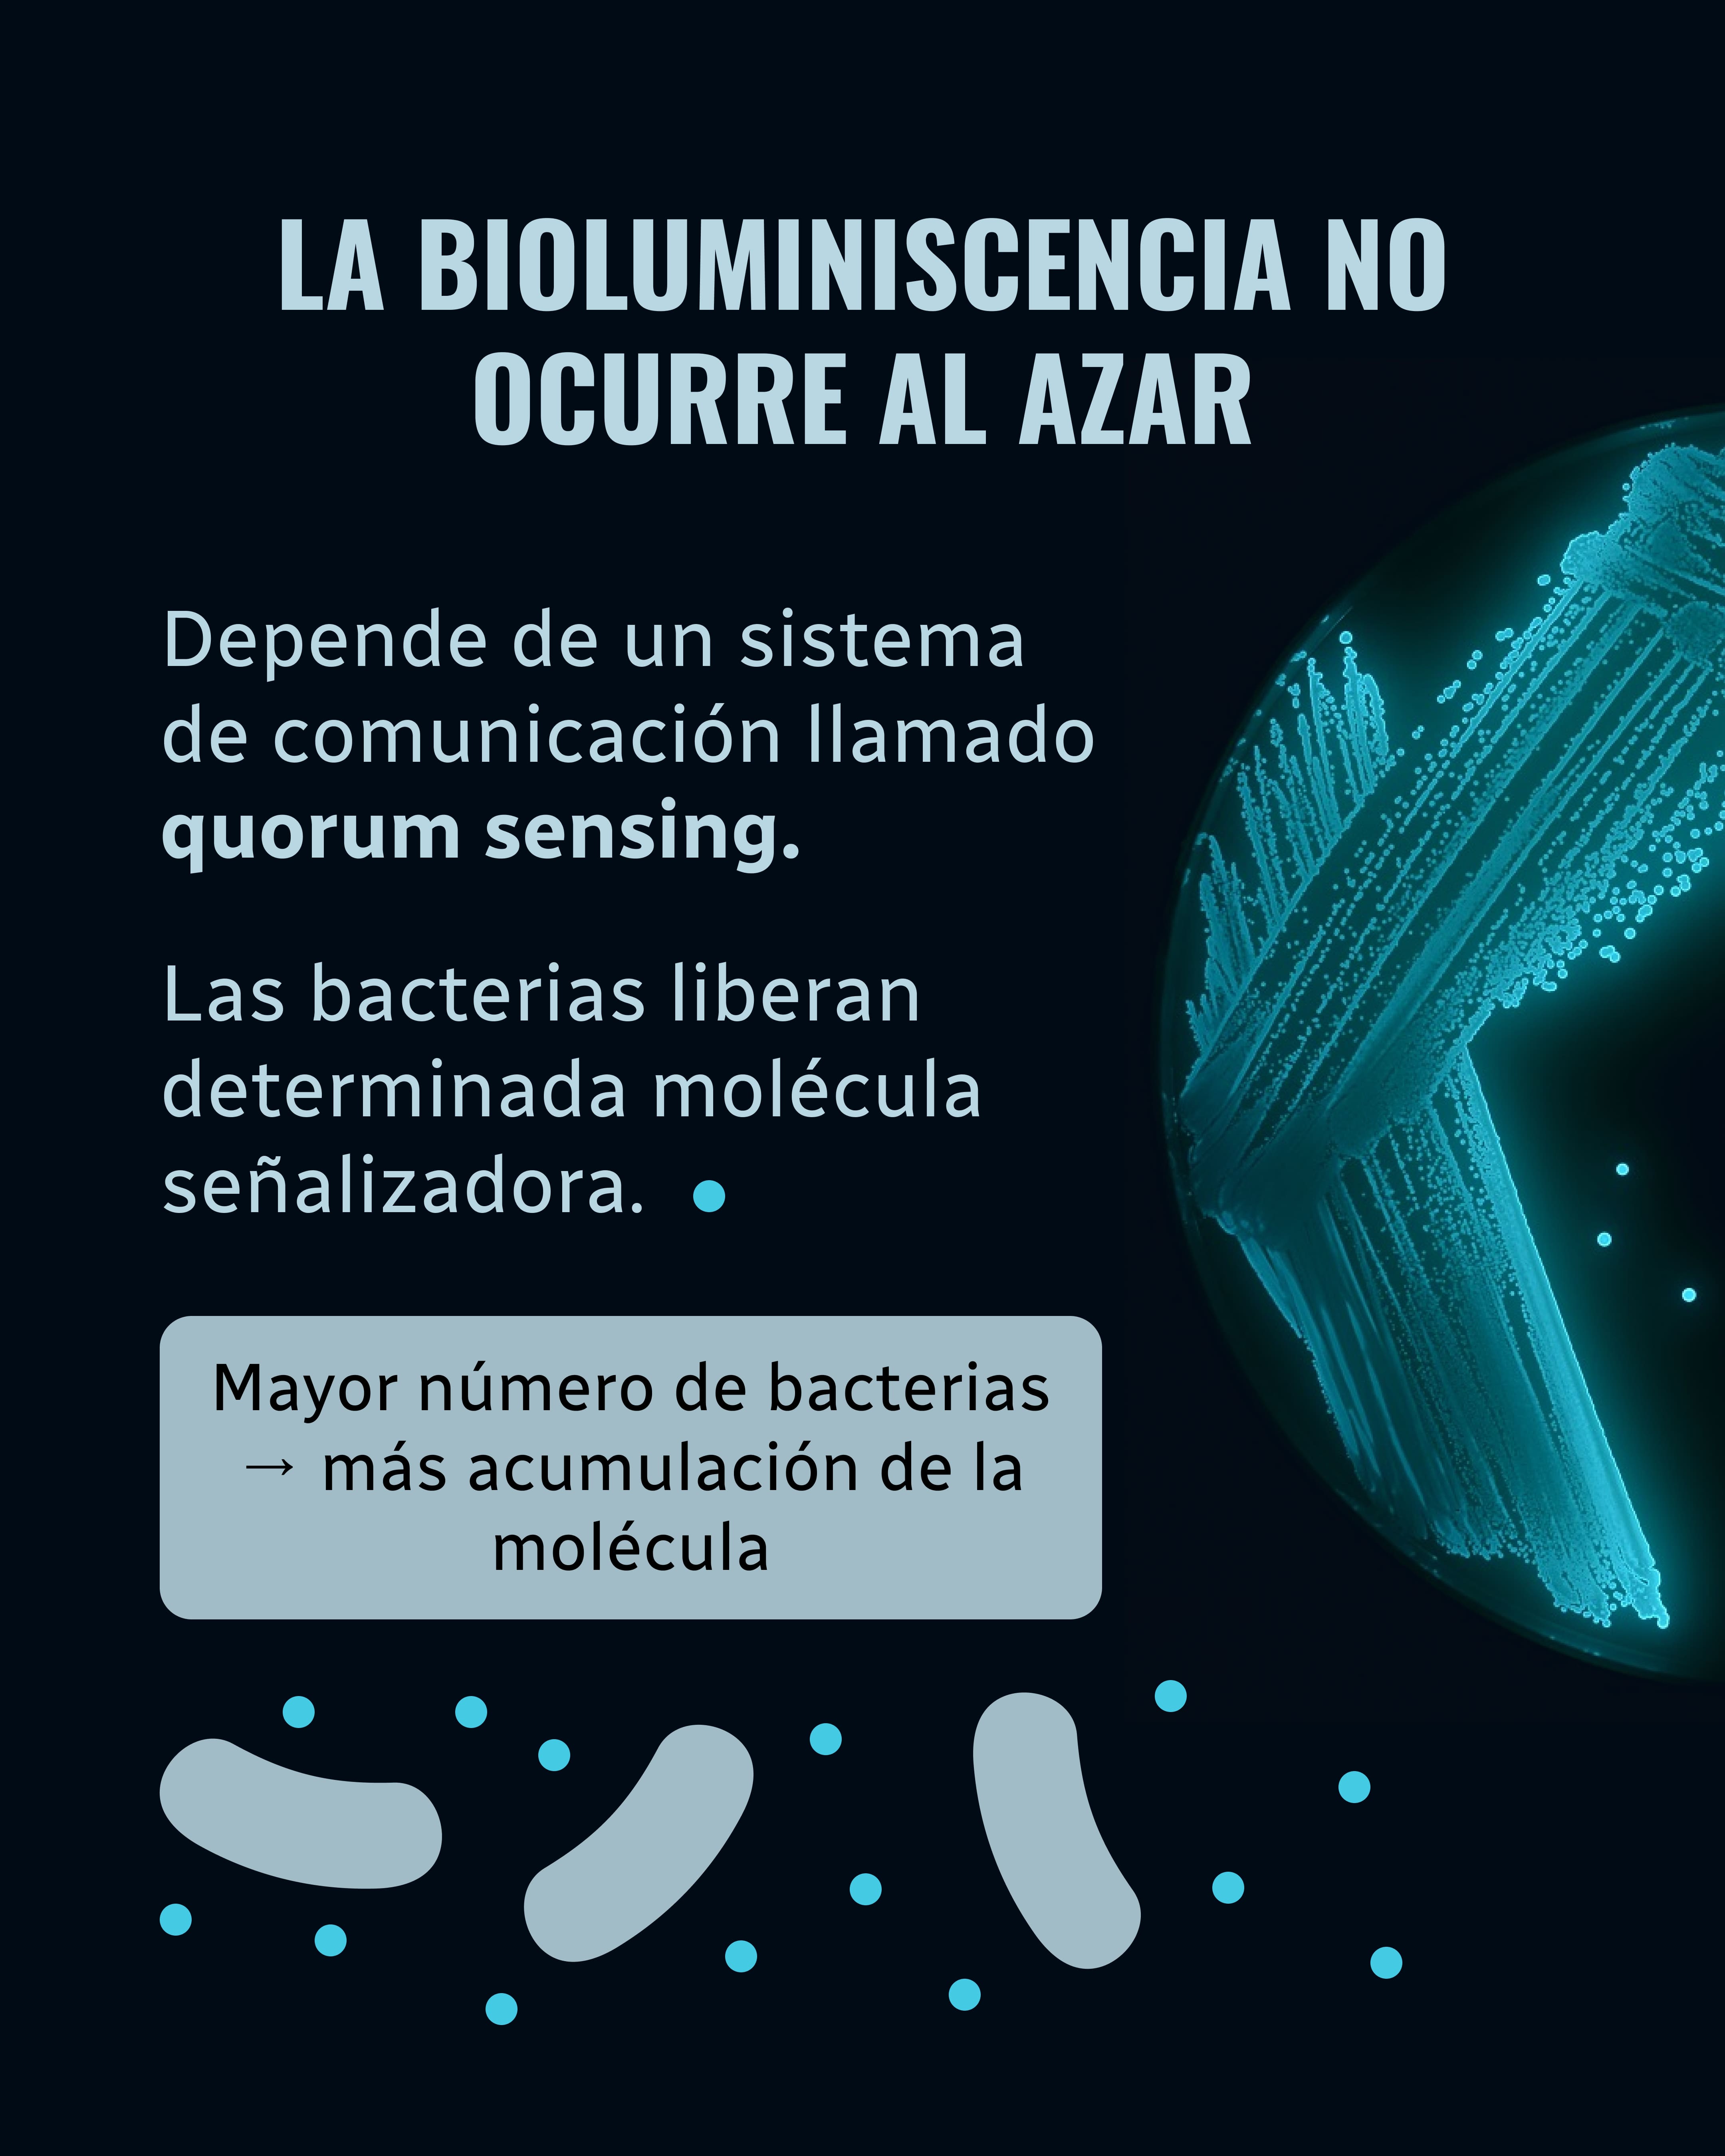
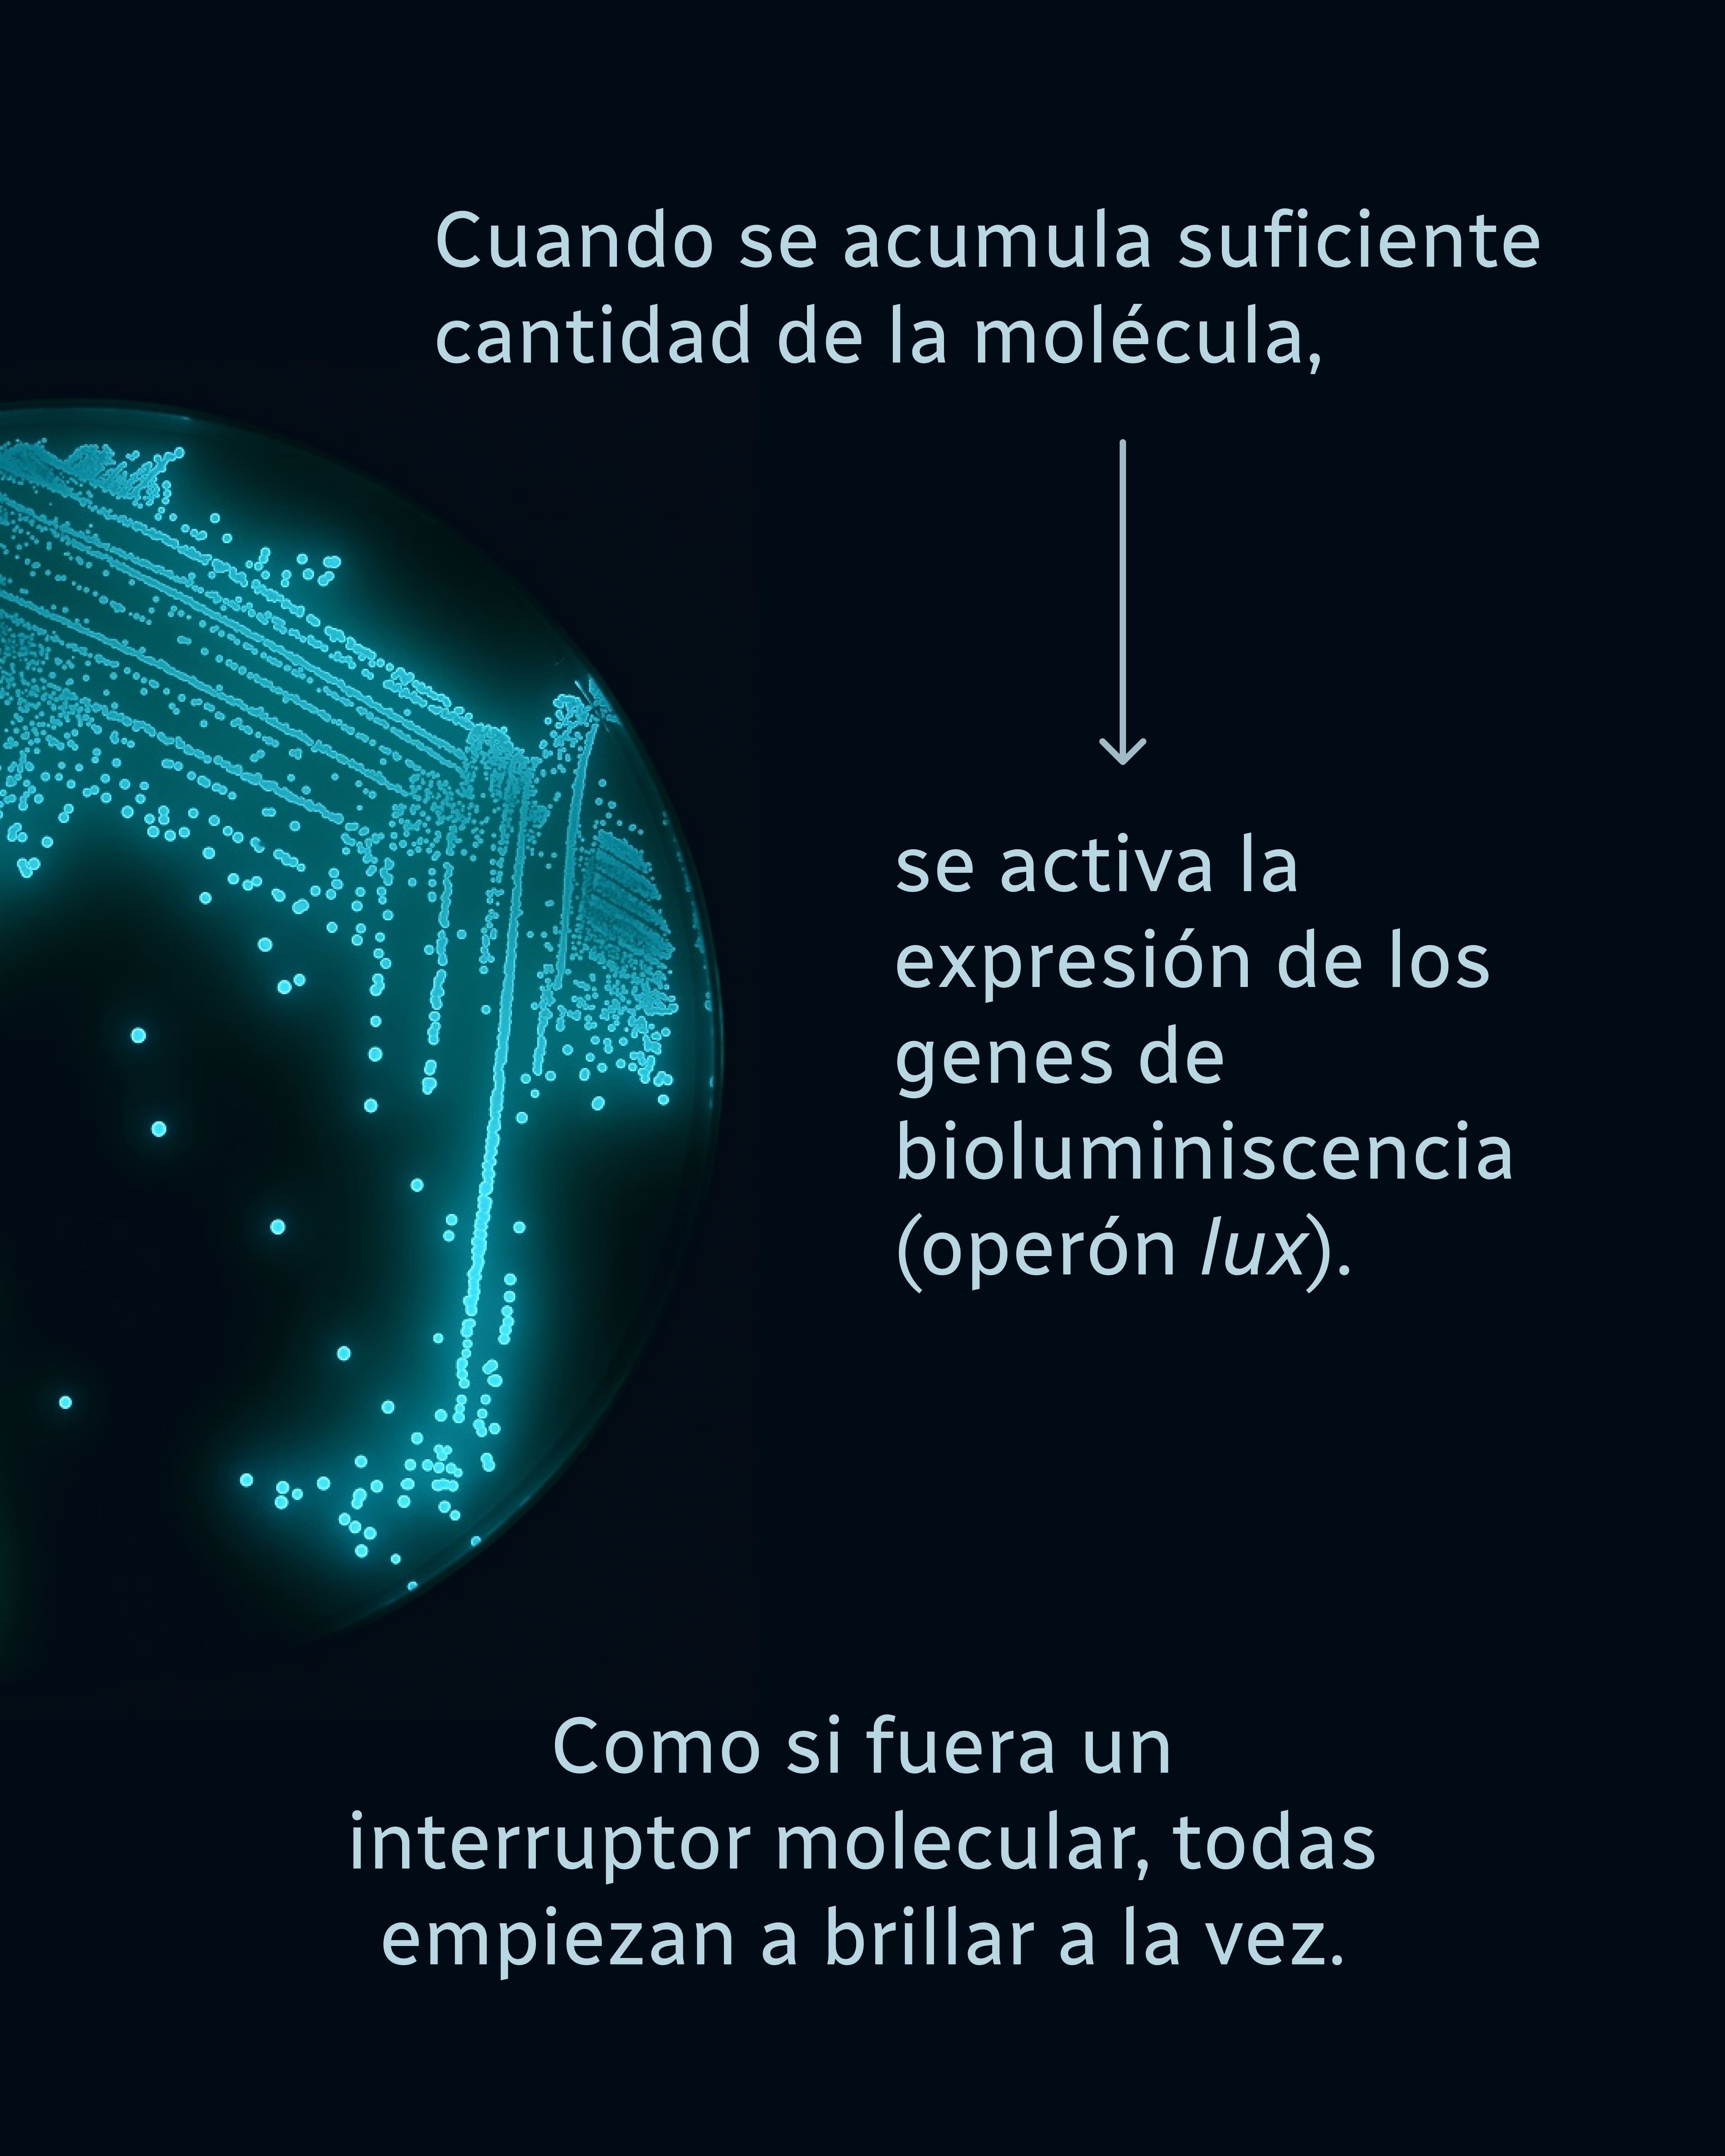

Microbiología
Una alianza que brilla en la oscuridad

Charo Céspedes Rubio
Biología | Bacteriología y Laboratorio Clínico | Microbiología Clínica
12 jun 2026
A veces, las alianzas más extraordinarias no se dan entre humanos…
sino entre un calamar y una bacteria luminosa.
Aliivibrio fischeri es más que una bacteria que brilla:
es una experta en comunicación, cooperación y biotecnología natural.
Y su historia, contada desde el fondo del mar, es un ejemplo de cómo la ciencia puede ser fascinante y poética a la vez.
Esta bacteria gram negativa vive en simbiosis con animales marinos como el calamar hawaiano, produciendo luz gracias a un sistema de quorum sensing:
una forma de “ponerse de acuerdo” con sus compañeras cuando hay suficientes para actuar en conjunto.
Ese brillo no es solo belleza: es camuflaje, supervivencia, y un fenómeno que ha inspirado aplicaciones científicas con gran impacto.
¿Te imaginabas que una bacteria podía brillar… y hacerlo por trabajo en equipo?